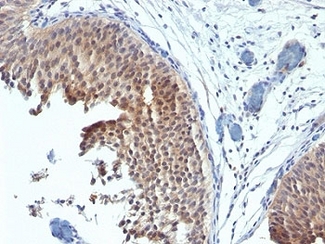

Cancer Research
Breast Cancer Immunohistochemistry Markers
ERBB2 / HER2
Anti-ERBB2 / HER2 antibody IHC of human breast, carcinoma. Immunohistochemistry of formalin-fixed, paraffin-embedded tissue after heat-induced antigen retrieval. Antibody LS-B2133 concentration 5 ug/ml.
Estrogen Receptor / ESR1
Anti-ER Alpha / Estrogen Receptor antibody IHC staining of human breast. Immunohistochemistry of formalin-fixed, paraffin-embedded tissue after heat-induced antigen retrieval. Antibody LS-B10527 dilution 1:100.
Progesterone Receptor / PGR
Anti-PGR / Progesterone Receptor antibody IHC of human uterus. Immunohistochemistry of formalin-fixed, paraffin-embedded tissue after heat-induced antigen retrieval. Antibody LS-B2983 concentration 20 ug/ml.
TP53
IHC of paraffin-embedded Carcinoma of Human lung tissue using anti-TP53 mouse monoclonal antibody.
EGFR
Anti-EGFR antibody IHC of human skin. Immunohistochemistry of formalin-fixed, paraffin-embedded tissue after heat-induced antigen retrieval. Antibody LS-B2914 concentration 5 ug/ml.
BRCA1
APOBEC3B
Ki-67 (MKI67)
CNN1 (Calponin)
Anti-CNN1 / Calponin antibody IHC of human myometrium. Immunohistochemistry of formalin-fixed, paraffin-embedded tissue after heat-induced antigen retrieval. Antibody LS-B4304 concentration 5 ug/ml.
Smooth Muscle Actin (SMA / ACTA2)
Anti-Smooth Muscle Actin antibody IHC of human prostate, smooth muscle. Immunohistochemistry of formalin-fixed, paraffin-embedded tissue after heat-induced antigen retrieval. Antibody LS-B7351 dilution 1:50.
SMMHC
Anti-Myosin, Smooth Muscle Heavy Chain antibody IHC of human prostate. Immunohistochemistry of formalin-fixed, paraffin-embedded tissue after heat-induced antigen retrieval. Antibody LS-B5148 concentration 20 ug/ml.
CK5 (KRT5)
CK7 (KRT7)
Anti-KRT7 / Cytokeratin 7 antibody IHC of human placenta. Immunohistochemistry of formalin-fixed, paraffin-embedded tissue after heat-induced antigen retrieval. Antibody LS-B7164 concentration 10 ug/ml.
CK14 (KRT14)
Anti-KRT14 / Cytokeratin 14 antibody IHC of human skin. Immunohistochemistry of formalin-fixed, paraffin-embedded tissue after heat-induced antigen retrieval. Antibody LS-B3916 dilution 1:25.
CK20 (KRT20)
Anti-KRT20 / Cytokeratin 20 antibody IHC staining of human small intestine. Immunohistochemistry of formalin-fixed, paraffin-embedded tissue after heat-induced antigen retrieval. Antibody LS-B10488 dilution 1:200.
E-Cadherin (CDH1)
Anti-E Cadherin antibody IHC of human liver. Immunohistochemistry of formalin-fixed, paraffin-embedded tissue after heat-induced antigen retrieval. Antibody LS-B4674 concentration 5 ug/ml. This image was taken for the unconjugated form of this product. Other forms have not been tested.
p120 (CTNND1)
FOXA1
Anti-FOXA1 antibody IHC of human prostate. Immunohistochemistry of formalin-fixed, paraffin-embedded tissue after heat-induced antigen retrieval. Antibody LS-B4356 concentration 5 ug/ml.
GATA3
Anti-GATA3 antibody IHC of human breast. Immunohistochemistry of formalin-fixed, paraffin-embedded tissue after heat-induced antigen retrieval. Antibody LS-B4163 dilution 1:200.
VEGFA
Anti-VEGF antibody IHC of human lung, vascular endothelium. Immunohistochemistry of formalin-fixed, paraffin-embedded tissue after heat-induced antigen retrieval. Antibody LS-B7747 dilution 5 ug/ml.
BCL2
CD31
Anti-CD31 antibody IHC of human placenta. Immunohistochemistry of formalin-fixed, paraffin-embedded tissue after heat-induced antigen retrieval. Antibody LS-B3446 dilution 1:200.
CD34
Anti-CD34 antibody IHC of human placenta. Immunohistochemistry of formalin-fixed, paraffin-embedded tissue after heat-induced antigen retrieval. Antibody LS-B2652 concentration 10 ug/ml.
SIAH2
Prolactin-induced protein (PIP / GCDFP-15)
Anti-PIP / GCDFP15 antibody IHC of human breast. Immunohistochemistry of formalin-fixed, paraffin-embedded tissue after heat-induced antigen retrieval. Antibody LS-B2498 concentration 5 ug/ml.
Mammaglobin A (SCGB2A2)
Anti-SCGB2A2 / Mammaglobin A antibody IHC of human breast. Immunohistochemistry of formalin-fixed, paraffin-embedded tissue after heat-induced antigen retrieval. Antibody LS-B3007 concentration 4 ug/ml.
PIM1
Anti-PIM1 antibody IHC of human adrenal. Immunohistochemistry of formalin-fixed, paraffin-embedded tissue after heat-induced antigen retrieval. Antibody LS-B5493 concentration 5 ug/ml.
Colorectal Cancer Immunohistochemistry Markers
GPA33 (A33)
CK20 (KRT20)
Anti-KRT20 / Cytokeratin 20 antibody IHC of human small intestine. Immunohistochemistry of formalin-fixed, paraffin-embedded tissue after heat-induced antigen retrieval. Antibody LS-B5959 dilution 1:50. This image was taken for the unconjugated form of this product. Other forms have not been tested.
CK7 (KRT7)
Anti-KRT7 / Cytokeratin 7 antibody IHC of human placenta. Immunohistochemistry of formalin-fixed, paraffin-embedded tissue after heat-induced antigen retrieval. Antibody LS-B7163 concentration 10 ug/ml.
Calretinin (CALB2)
CDH17
Anti-CDH17 / LI Cadherin antibody IHC of human small intestine. Immunohistochemistry of formalin-fixed, paraffin-embedded tissue after heat-induced antigen retrieval. Antibody LS-B6022 concentration 5 ug/ml.
Cyclooxygenase 2 (COX-2 / PTGS2)
Anti-COX-2 antibody IHC of human kidney. Immunohistochemistry of formalin-fixed, paraffin-embedded tissue after heat-induced antigen retrieval. Antibody LS-B1608 concentration 5 ug/ml.
MUC2
Anti-MUC2 antibody IHC of human intestine. Immunohistochemistry of formalin-fixed, paraffin-embedded tissue after heat-induced antigen retrieval. Antibody LS-B5562 dilution 1:100.
CDX2
Anti-CDX2 antibody IHC of human colon. Immunohistochemistry of formalin-fixed, paraffin-embedded tissue after heat-induced antigen retrieval. Antibody LS-B1514 concentration 5 ug/ml. This image was taken for the unconjugated form of this product. Other forms have not been tested.
Villin
Anti-Villin antibody IHC of human small intestine, epithelial membrane. Immunohistochemistry of formalin-fixed, paraffin-embedded tissue after heat-induced antigen retrieval. Antibody LS-B8547 dilution 10 ug/ml.
MOC-31 (EPCAM)
Anti-EPCAM antibody IHC of human intestine. Immunohistochemistry of formalin-fixed, paraffin-embedded tissue after heat-induced antigen retrieval. Antibody LS-B5565 dilution 1:100.
CEA / Carcinoembryonic Antigen
Anti-CEA antibody IHC of human colon. Immunohistochemistry of formalin-fixed, paraffin-embedded tissue after heat-induced antigen retrieval. Antibody LS-B7173 concentration 10 ug/ml.
SATB2
Anti-SATB2 antibody IHC of human brain, cortex. Immunohistochemistry of formalin-fixed, paraffin-embedded tissue after heat-induced antigen retrieval. Antibody LS-B4981 concentration 5 ug/ml.
Carbohydrate antigen (CA19-9/FUT)
TP53
Anti-p53 antibody IHC of human placenta. Immunohistochemistry of formalin-fixed, paraffin-embedded tissue after heat-induced antigen retrieval. Antibody LS-B7722 dilution 10 ug/ml.
BRAF
PIK3CA
Anti-PIK3CA antibody IHC of human liver. Immunohistochemistry of formalin-fixed, paraffin-embedded tissue after heat-induced antigen retrieval. Antibody LS-B5363 concentration 5 ug/ml.
RECQL4
Adenomatous Polyposis Coli (APC)
MLH1
Anti-MLH1 antibody IHC of human small intestine. Immunohistochemistry of formalin-fixed, paraffin-embedded tissue after heat-induced antigen retrieval. Antibody LS-B3475 dilution 1:200.
MSH2
Anti-MSH2 antibody IHC of human breast. Immunohistochemistry of formalin-fixed, paraffin-embedded tissue after heat-induced antigen retrieval. Antibody LS-B1973 concentration 5 ug/ml.
MSH6
Anti-MSH6 antibody IHC staining of human testis. Immunohistochemistry of formalin-fixed, paraffin-embedded tissue after heat-induced antigen retrieval. Antibody LS-B10739 dilution 1:50.
PMS2
Anti-PMS2 antibody IHC of human breast. Immunohistochemistry of formalin-fixed, paraffin-embedded tissue after heat-induced antigen retrieval. Antibody LS-B1980 concentration 5 ug/ml.
AXIN1
Anti-AXIN1 / AXIN antibody IHC of human adrenal. Immunohistochemistry of formalin-fixed, paraffin-embedded tissue after heat-induced antigen retrieval. Antibody LS-B2741 concentration 75 ug/ml.
AXIN2
Anti-AXIN2 / AXIL antibody IHC of human uterus. Immunohistochemistry of formalin-fixed, paraffin-embedded tissue after heat-induced antigen retrieval. Antibody LS-B7029 concentration 5 ug/ml.
TCF7L2
Lung Cancer Immunohistochemistry Markers
PDL1 (CD274)
Anti-B7-H1 / PD-L1 / CD274 antibody IHC staining of human testis. Immunohistochemistry of formalin-fixed, paraffin-embedded tissue after heat-induced antigen retrieval. Antibody LS-B10562 dilution 1:100.
PD1 (PDCD1 / CD279)
Anti-CD279 / PD-1 antibody IHC of human tonsil. Immunohistochemistry of formalin-fixed, paraffin-embedded tissue after heat-induced antigen retrieval. Antibody LS-B7883 dilution 20 ug/ml.
AHR
Anti-Aryl Hydrocarbon Receptor antibody LS-A3018 IHC of human respiratory epithelium and bronchial smooth muscle. Immunohistochemistry of formalin-fixed, paraffin-embedded tissue after heat-induced antigen retrieval.
Surfactant Protein A (SFTPA1)
Anti-SFTPA1 / Surfactant Protein A antibody IHC of human lung. Immunohistochemistry of formalin-fixed, paraffin-embedded tissue after heat-induced antigen retrieval. Antibody LS-B2543 concentration 10 ug/ml.
SOX2
Anti-SOX2 antibody IHC of human kidney. Immunohistochemistry of formalin-fixed, paraffin-embedded tissue after heat-induced antigen retrieval. Antibody LS-B4562 concentration 5 ug/ml.
APOBEC3B
MET
Anti-c-Met antibody IHC of human uterus. Immunohistochemistry of formalin-fixed, paraffin-embedded tissue after heat-induced antigen retrieval. Antibody LS-B2812 concentration 10 ug/ml.
CK5 (KRT5)
Anti-KRT5 / CK5 / Cytokeratin 5 antibody IHC staining of human skin, epidermis. Immunohistochemistry of formalin-fixed, paraffin-embedded tissue after heat-induced antigen retrieval.
CK6 (KRT6)
Formalin-fixed, paraffin-embedded human bladder carcinoma stained with Cytokeratin 6 antibody (SPM269). This image was taken for the unmodified form of this product. Other forms have not been tested.
Chromogranin A (CHGA)
Anti-CHGA / Chromogranin A antibody IHC of human adrenal. Immunohistochemistry of formalin-fixed, paraffin-embedded tissue after heat-induced antigen retrieval. Antibody LS-B6265 dilution 1:200.
NKX2-1 (TTF-1)
Anti-TTF1 / TTF-1 / NKX2-1 antibody IHC staining of human lung. Immunohistochemistry of formalin-fixed, paraffin-embedded tissue after heat-induced antigen retrieval. Antibody LS-B10666 dilution 1:100.
CD56 (NCAM1)
Anti-CD56 antibody IHC of human intestine, ganglion cells. Immunohistochemistry of formalin-fixed, paraffin-embedded tissue after heat-induced antigen retrieval. Antibody LS-B5569 dilution 1:100.
DSG3
Synaptophysin (SYP)
Napsin A
NAPSIN1 Antibody (TMU-Ad02) – IHC of Napsin1 on human lung adenocarcinoma. This image was taken for the unconjugated form of this product. Other forms have not been tested.
EGFR
Anti-EGFR antibody IHC of human prostate. Immunohistochemistry of formalin-fixed, paraffin-embedded tissue after heat-induced antigen retrieval. Antibody LS-B2199 concentration 5 ug/ml.
KRAS
Anti-KRAS antibody IHC of human placenta. Immunohistochemistry of formalin-fixed, paraffin-embedded tissue after heat-induced antigen retrieval. Antibody LS-B4683 concentration 5 ug/ml. This image was taken for the unconjugated form of this product. Other forms have not been tested.
Prostate Cancer Immunohistochemistry Markers
ACPP (PSAP)
Anti-Prostatic Acid Phosphatase antibody IHC of human prostate. Immunohistochemistry of formalin-fixed, paraffin-embedded tissue after heat-induced antigen retrieval. Antibody LS-B3108 concentration 5 ug/ml.
AMACR
CDKN1B
ELAC2
Anti-ELAC2 antibody IHC of human breast, epithelium. Immunohistochemistry of formalin-fixed, paraffin-embedded tissue after heat-induced antigen retrieval. Antibody LS-B5670 dilution 1:100.
FOLH1 (PSMA)
Anti-FOLH1 / PSMA antibody IHC of human prostate. Immunohistochemistry of formalin-fixed, paraffin-embedded tissue after heat-induced antigen retrieval. Antibody LS-B2542 concentration 10 ug/ml.
FOXA1
Anti-FOXA1 antibody IHC of human prostate. Immunohistochemistry of formalin-fixed, paraffin-embedded tissue after heat-induced antigen retrieval. Antibody LS-B6101 concentration 5 ug/ml.
MSMB
Prostein (SLC45A3 / p501S)
Prostate Specific Antigen (KLK3)
Anti-KLK3 / PSA antibody IHC of human prostate. Immunohistochemistry of formalin-fixed, paraffin-embedded tissue after heat-induced antigen retrieval. Antibody LS-B3470 dilution 1:200.